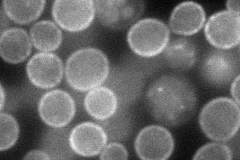
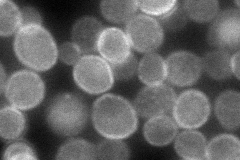
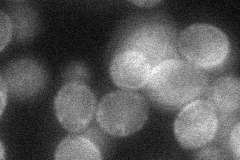
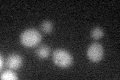

View description
Purine-cytosine permease, mediates purine (adenine, guanine, and hypoxanthine) and cytosine accumulation
Localization:
Intensity:
Fold change:
Significance:
-
C’ GFP library in SD

below threshold17.22 -
N' NOP1pr-GFP in SD
cell periphery85.7847 -
N' TEF2pr-mCherry in SD

cell periphery,vacuole133.723 -
N' NATIVEpr-GFP in SD
cell periphery102.326 -
N' TEF2pr-VC and Cyto-VN in SD
cell periphery37.7736 -
C’ GFP library in SD+DTT
cytosol13.290.77No -
C’ GFP library in SD+H2O2

cytosol14.470.84No -
C’ GFP library in Starvation Media

cytosol18.011.04No -
C’ GFP library on the background of Pup2-DaMP

below threshold -
C’ GFP library on the background of CCT mutant

below threshold15.0490.873508No
